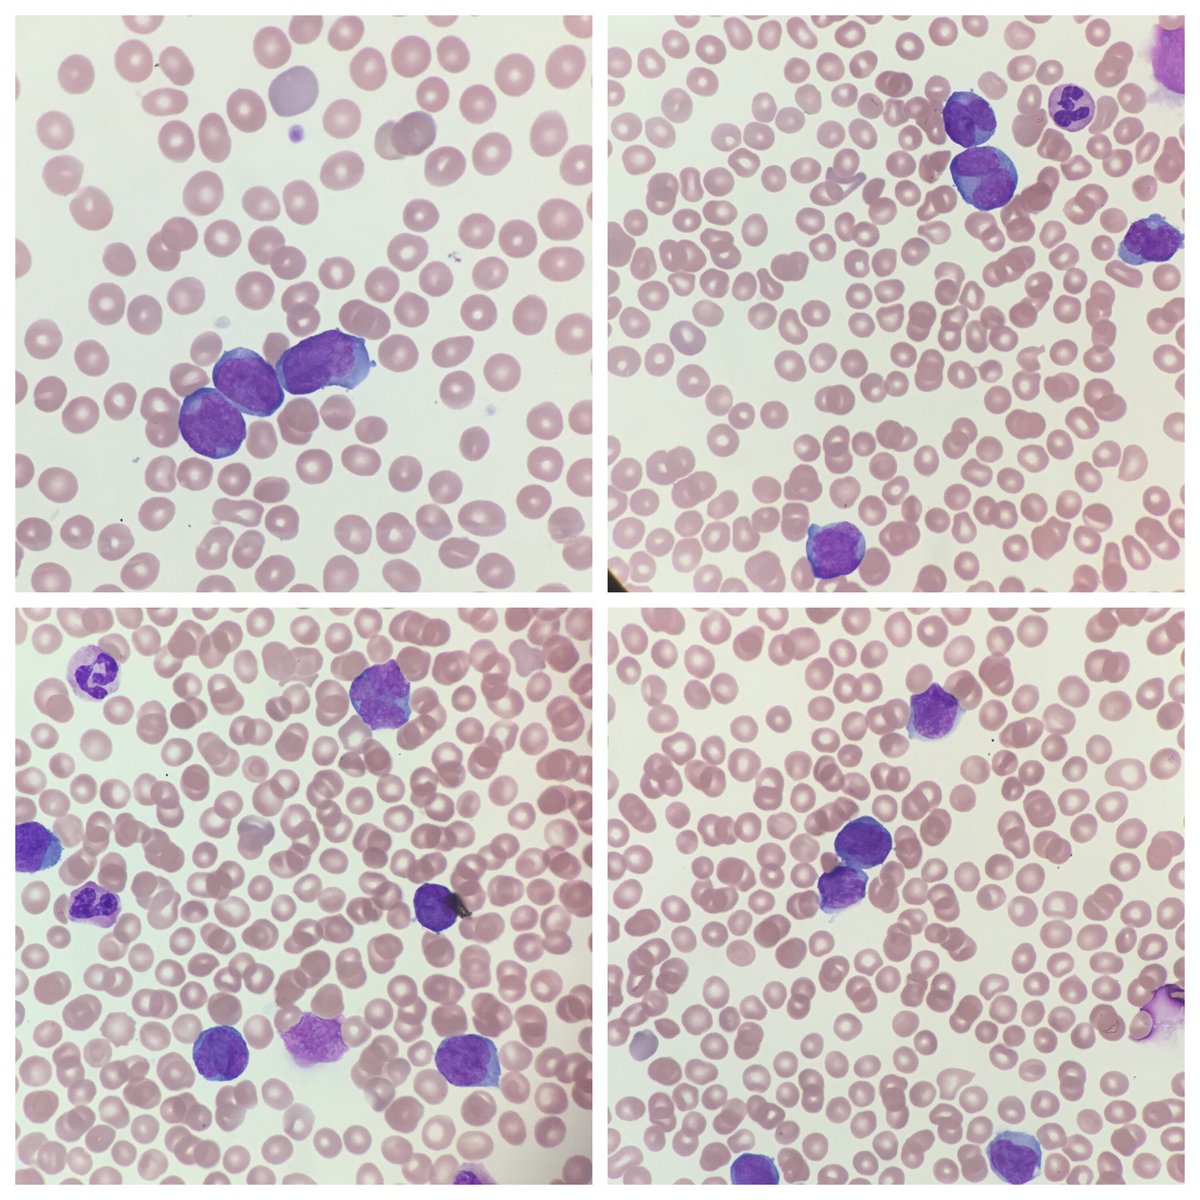
bluehatcomics85's tweet image. Its an amazing feeling to be able to come to the hospital late-night,diagnose AML and work with the Heme-Onc team to guide treatment for our patient. #IAmAPathologist#Enlight #hemepath @SUNYUpstatePath⁩ ⁦@DrFNA⁩ ⁦@smlungpathguy⁦@mjcascio⁩ ⁦@IUraizee3MD⁩

#iamapathologist search results
One of my favorite holiday pastimes is staying late signing out as many cases as possible and texting surgeons with benign diagnoses so that they can call their patients and they can enjoy the holidays more! #IAmAPathologist #DoctorsDoctor @MGHPathology @MGHSurgery @MassEyeAndEar
Beautiful and Informative! #Iamapathologist #pathology #PathArt
It’s #PathFigureFriday! 🔬 Please add any comments, corrections, or creations of your own! Continuing the “Patient Interface” series…#PathXPatient! 👩🏻⚕️ #PathTwitter #PathX #MedX #SurgPath #Autopsy #Cytopath #FNA #LabMedicine #TransfusionMedicine More: kikoxp.com/posts/27708

Location of lesion: Oropharynx, thyroid, salivary gland, etc: up to 4 slides with index card w clin history, dx on back side, for teaching. Res/fellows can borrow. Hope to digitize before coverslips fall off #MedEd #IAmAPathologist
#beautiful #graphicmedicine #iamapathologist #ilooklikeapathogist @smlungpathguy @kis_lorand @vi_monappa @VijayPatho @DrGeeONE @tralimiguel
Newest piece in my #graphicmedicine in #pathology and #labmedicine: the critical value of #medicallaboratoryscientists! They’re the team behind the scenes delivering high-quality results to help care for patients, everyday! I am (a proud) one—I should know!🔬🧬🦠🧫 #path2path

We forgive our colleagues who don’t interact w us. My office is on the 10th floor w a bangin’ view. Stereotypes in medicine are fun & often amusing. I’ll visit the basement on occasion, but I am comfortable where I belong. #AtTheTop #IAmAPathologist Love u, Chief Sareh!

Morning #PathTwitter and #MedTwitter ! The best midnight frozen section experience as a pathology resident is when you get to call in the diagnosis and hear the gratitude from the surgical team for helping to achieve the best care for the patient 😊😊 #IAmAPathologist
Really great meeting you both! #IAmAPathologist
I love that it lists your favorite cell. Good call. #PathNerds #PathArt #IAmAPathologist Favorite Cell: Thyrocyte
Educating clinicians and explaining path results (bronchial carcinoide, margin) #iamapathologist #pulmpath #pulmonarypath #pathology @microvisioneer


Deep breath, longer days, more sunshine, & vision for the long haul. Look past these thorns blocking the trail, realizing that there are always little treacheries. Pass them toward such beautiful sights & adventures ahead for you, young sapling! #Path2Path #IAmAPathologist 🔬🧠🤓
Pathologists are all about vivisection, especially post-Easter. 🐣🐰🐇🌺🌼🔬#IAmAPathologist #pathology #FirstTheyCameForMyEars .@MGHPathology #MovingTheFieldForward



Dear #RisingPathologists, welcome to the next phase of your pathological evolution. We @MGHPathology will welcome our #NeoplasticNine on Friday, &we welcome all of you to this exciting phase of your evolution! #IAmAPathologist #Path2Path 🔬🧬 #VirtualPathMatch #Match2020
Dear #Path2Path #medstudenttwitter - ur #pathology tweeple are excited to celebrate #Match2020 with you! Its easy! When you are ready to share your Match news write a post and/or post a picture and include #VirtualPathMatch - Your #PathTwitterFamily will celebrate with you! RT!

Its an amazing feeling to be able to come to the hospital late-night,diagnose AML and work with the Heme-Onc team to guide treatment for our patient. #IAmAPathologist#Enlight #hemepath @SUNYUpstatePath @DrFNA @smlungpathguy@mjcascio @IUraizee3MD

What about social awkwardness? I’ve been doing that for years. I’ve heard social awkwardness is a precursor lesion for social distancing. #IAmAPathologist
Another case solved by the anatomic and clinical pathology laboratory at @UCLAHealth. #uclapathology #pathologistsmatter #iamapathologist
Today is the 200th birthday of #RudolfVirchow , the father of modern Pathology. @ArgosPatologia celebrates this important date. #pathology is the link between science and medicine. #iamapathologist

Glad you're not leaving - I thought I hadn't heard from you for a while #ILookLikeAPathologist #IAmAPathologist #OnceAPathologistAlwaysAPathologist
Amazing selfie with @ALBoothMD and @KMirza !! #ASCPiSpy #ASCP2019 @SUNYUpstatePath @ASCP_Chicago @smlungpathguy @DrFNA #IAmAPathologist #WeArePathologist #hemepath #GIpath

Congratulations to our graduates! You will all do AMAZING things! The future is bright 💡👏👍#virtualgraduation #iamapathologist #pathology @cbsirini @PhoenixBellMD @MushalNoor6 - Looking to have you join us in July @roula_katerji !

Today is the 203rd birthday of Rudolf Ludwig Karl Virchow , the father of Modern Pathology. Celebrate this important date. Pathology is the link between science and medicine. 🔬 #iamapathologist

Beautiful and Informative! #Iamapathologist #pathology #PathArt
It’s #PathFigureFriday! 🔬 Please add any comments, corrections, or creations of your own! Continuing the “Patient Interface” series…#PathXPatient! 👩🏻⚕️ #PathTwitter #PathX #MedX #SurgPath #Autopsy #Cytopath #FNA #LabMedicine #TransfusionMedicine More: kikoxp.com/posts/27708

Really great meeting you both! #IAmAPathologist
@Pathologists provides the support and resources to build their members into #leaders #CAPELA23 #IamAPathologist #REPRESENTOINMATTERS




I had a post-surgical fever stay febrile after transferring to the ICU following being given every big gun ABX rather than giving incentive spirometry before being thanked for my care of the patient. 😂 #ReassurePatient #IAmAPathologist #SimulatedPatients
We are Pathology, the best in medicine, the most empathic, just and courteous. Not so social, but nobody's perfect. #iamapathologist
Today is the 200th birthday of #RudolfVirchow , the father of modern Pathology. @ArgosPatologia celebrates this important date. #pathology is the link between science and medicine. #iamapathologist

this week’s #hemepathMDA live 🎙 from R4.2371 in 15 mins.. 🔬🧬 🙏🏻 @Pathologists for my 👌🏻👌🏻 Tshirt to officiate the event! #IAmAPathologist 🩸Meeting➡️ bit.ly/3xLyk72 🩸Password➡️ SjT2AyUpD27 🩸Digital slides➡️ bit.ly/2PM9J0X #PathTwitter #leusm #hemepath

Morning #PathTwitter and #MedTwitter ! The best midnight frozen section experience as a pathology resident is when you get to call in the diagnosis and hear the gratitude from the surgical team for helping to achieve the best care for the patient 😊😊 #IAmAPathologist
Take a photo at the microscope and you are in a gang. Photos by different authors,my selection,Google collage. #IPD2020 #IamaPathologist

Dear patient, I carefully reviewed all the cells in your bone marrow and lymph node. I make sure your clinician has enough information To treat you!You’ll never meet me, but I care about you deeply. #IamAPathologist
#healthcare #Ilooklikeapathologist #iamapathologist #hematopathologist proof from my camera roll i work in healthcare



When enemy is bigger than the weapon we have😃#fellowlife @feldstej @drdatari @AdhikariTwisha #ILookLikeAPathologist #IAmAPathologist

Proof from my camera roll I work in healthcare #ILookLikeAPathologist #IAmAPathologist



Proof from my cell phone camera roll that I work in healthcare. Show me your. #ILookLikeAPathologist

We forgive our colleagues who don’t interact w us. My office is on the 10th floor w a bangin’ view. Stereotypes in medicine are fun & often amusing. I’ll visit the basement on occasion, but I am comfortable where I belong. #AtTheTop #IAmAPathologist Love u, Chief Sareh!

Anion gap, acute glomerulonephritis, transplant biopsies with drug reaction changes #iamapathologist
Congratulations to our graduates! You will all do AMAZING things! The future is bright 💡👏👍#virtualgraduation #iamapathologist #pathology @cbsirini @PhoenixBellMD @MushalNoor6 - Looking to have you join us in July @roula_katerji !

Glad you're not leaving - I thought I hadn't heard from you for a while #ILookLikeAPathologist #IAmAPathologist #OnceAPathologistAlwaysAPathologist
Location of lesion: Oropharynx, thyroid, salivary gland, etc: up to 4 slides with index card w clin history, dx on back side, for teaching. Res/fellows can borrow. Hope to digitize before coverslips fall off #MedEd #IAmAPathologist
learning is fun. "tripping over the truth" by travis christopherson #iamapathologist #pathology @ArgosPatologia

Its an amazing feeling to be able to come to the hospital late-night,diagnose AML and work with the Heme-Onc team to guide treatment for our patient. #IAmAPathologist#Enlight #hemepath @SUNYUpstatePath @DrFNA @smlungpathguy@mjcascio @IUraizee3MD
Today is the 200th birthday of #RudolfVirchow , the father of modern Pathology. @ArgosPatologia celebrates this important date. #pathology is the link between science and medicine. #iamapathologist

Starting the day with a good interstitial lung disease using @pathpresenter #pulmpath #pulmonarypathology #iamapathologist

@Pathologists provides the support and resources to build their members into #leaders #CAPELA23 #IamAPathologist #REPRESENTOINMATTERS



Glad you're not leaving - I thought I hadn't heard from you for a while #ILookLikeAPathologist #IAmAPathologist #OnceAPathologistAlwaysAPathologist
Had the honor of presenting this morning (on a Saturday!) to our lab staff for their CEU credits to celebrate the end of #labweek. #pathologistsmatter #iamapathologist #plateletrefractoriness #CEUs

We forgive our colleagues who don’t interact w us. My office is on the 10th floor w a bangin’ view. Stereotypes in medicine are fun & often amusing. I’ll visit the basement on occasion, but I am comfortable where I belong. #AtTheTop #IAmAPathologist Love u, Chief Sareh!

Amazing selfie with @ALBoothMD and @KMirza !! #ASCPiSpy #ASCP2019 @SUNYUpstatePath @ASCP_Chicago @smlungpathguy @DrFNA #IAmAPathologist #WeArePathologist #hemepath #GIpath

Educating clinicians II, pathologists job {renal sinus venous invasion} #iamapathologist #gupath @GU_Path_Society @ArgosPatologia

Pathologists are all about vivisection, especially post-Easter. 🐣🐰🐇🌺🌼🔬#IAmAPathologist #pathology #FirstTheyCameForMyEars .@MGHPathology #MovingTheFieldForward



Educating clinicians and explaining path results (bronchial carcinoide, margin) #iamapathologist #pulmpath #pulmonarypath #pathology @microvisioneer


Not an everyday case when a thoracic and gu pathologist has to deal with a lobular breast ca metastatic to the stomach mimicking signet rings #gipath @DoraGIPath #iamapathologist

When enemy is bigger than the weapon we have😃#fellowlife @feldstej @drdatari @AdhikariTwisha #ILookLikeAPathologist #IAmAPathologist

Every time I have a prostate bx with a small focus of 3+3 less than 5%, I include a picture in the report. Here are some from 2018 #uropathology #gupath #iamapathologist


Today is the 203rd birthday of Rudolf Ludwig Karl Virchow , the father of Modern Pathology. Celebrate this important date. Pathology is the link between science and medicine. 🔬 #iamapathologist

Something went wrong.
Something went wrong.
United States Trends
- 1. #dropdead N/A
- 2. #thepitt N/A
- 3. Olivia Rodrigo N/A
- 4. Robby N/A
- 5. #KONNAKOL N/A
- 6. Universal High Income N/A
- 7. Mason Miller N/A
- 8. #deathvegasinvi N/A
- 9. #PRAGMATA N/A
- 10. Asteroid N/A
- 11. LiDAR N/A
- 12. Tyla and Zara N/A
- 13. FISA N/A
- 14. Salad N/A
- 15. SONG OF THE YEAR N/A
- 16. Doomsday N/A
- 17. Connor Joe N/A
- 18. Versailles N/A
- 19. Hannity N/A
- 20. Dan Wilson N/A
























